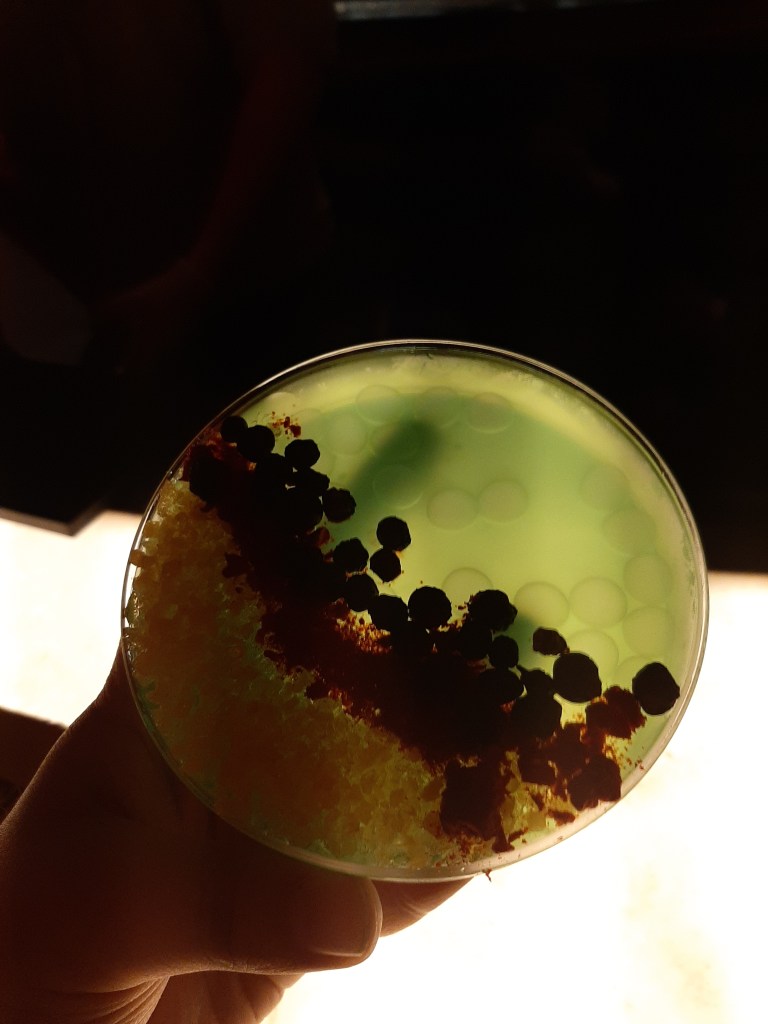

What’s that? Another blog post about my trip to Florida? YES IT IS! This post is the one I have been looking forward to writing the most, and it’s a breakdown of what I actually got up to on my travels. In the lead up to my trip, I spent a lot of (re. Most of) of my time reading posts like this, to a) get me in the holiday spirit and b) to pick up on other people’s tips and tricks. So, I thought it was time for me to write my own! (This post will be split into three parts, as it’ll be far too lengthy to fit it all in one post…)
We visited Florida in November 2019, after months of saving and planning; this included cutting down on date nights, planning each day of the trip 180 days beforehand, and generally a lot of spreadsheets. As a plan-aholic, I was thriving. Still, all the saving and planning paid off and we began our trip on Saturday 2nd November.


Saturday 2nd November – Travel
Like a child on Christmas Day, I didn’t really get a lot of sleep the night before traveling. We left the house at 6am, jumped on the train to Gatwick Airport in time for our late morning flight. Thanks to the BA Disability team, we were all checked in and had our seats confirmed (the only perks of having a life threatening allergy), so we dropped our bags, moved swiftly through security, and settled down for the darn best Wetherspoon’s breakfast I’ve ever had.
When it came to boarding the plane, my allergy meant I had pre-boarding, which gave us time to wipe down everything near our seats and let the cabin crew know where I was sitting. All that was left was to sit through the allergy/’please do not eat nuts on this flight’ message, and it was time for take off. The journey took just over 9 hours, and was enjoyable, as far as plane journeys go. We landed at 17.25 at Orlando International Airport, and spent over two hours going through US Security and bag collection (thank Heavens for adrenaline for getting us through that).


Once we escaped bag collection, that’s when the holiday really began. As we were staying on Disney property, we had free coach transfers to the hotel in the form of Disney’s Magical Express. On the Magical Express, I sat either with my face glued to the window watching Florida pass by, looking at the Disney World videos being played in the coach, or tapping my boyfriend’s arm and whispering ‘I can’t believe we are here!’. As a child, I was so lucky to get to go to Florida and Walt Disney World with my family, so I had all of those wonderful and exciting memories stored up.
The rest of that evening was a bit of a blur. We got to our hotel, All Star Sport’s Resort, checked in, and went straight to the room. We were staying at the Homerun Hotel section in a standard room; two queen beds, an ensuite, fridge, TV, and a lot of space for two people. We haphazardly unpacked, got some dinner from the food court, set our alarms and at 11pm Florida time (4am UK time) we completely crashed.
Sunday 3rd November – Magic Kingdom
You can’t go to Disney World and not visit Magic Kingdom as the first park (I’m sorry, I don’t make the rules)! Thanks to jet lag, we were up at 5.30am and before our alarms, which gave us a lot of time to get ready for our first day. We had a breakfast reservation for The Plaza Restaurant in Magic Kingdom at 8.30am, so got the first bus from our hotel at 7.45am, which should have left more than enough time to get to the Magic Kingdom, take photos on Main Street, and get to the restaurant. Except, things never really go to plan, do they? What we didn’t know was that it was the Disney Wine & Dine Half Marathon event that morning, which closed a lot of roads on Disney property. What should have been a 20 minute bus trip turned into an hour and a quarter bus trip, complete with a very panicked Rosie and Rory. Once we got to Magic Kingdom, we ran off the bus, sped through security, and landed at Main Street USA.



I am twenty three years old, have a full time job, a degree, live on my own, and pay taxes. I, that twenty-three year old woman, saw the castle at the end of Main Street USA and burst into tears. The power of jetlag and Disney, folks. Through tears and shouts of ‘oh my GOSH THIS IS AMAZING’ we got to the Plaza Restaurant, and they upheld our reservation, no problem. Cue the best way to start a day, ever. We were sat with views of the castle, were given an allergy friendly menu, and ended up having a delicious waffle breakfast.
After The Plaza, the day went according to plan. Starting at Adventureland, we made our way around, and by 2pm we had already ridden Pirates of the Carribean, The Haunted Mansion, Big Thunder Railway, explored Tom Sawyer’s Island and the shops, nooks and crannies. If there’s one thing I will say about Disney food, it’s that the portions are huge. We were still full from breakfast, so forgoed my plan of eating at Peco’s Bill’s, and grabbed some fried chicken and waffles fries from the Golden Oak Outpost to share. We knew the weather was going to be warm (it’s Florida; it’s literally the Sunshine State) but there seemed to be a heat spike when we were there. The temperature ended hitting about 28 degrees that day, just as we had grabbed a spot for the parade.



If you thought crying at the castle was bad, you should have seen me weep at the parade. It was half an hour of pure nostalgia, and I am not ashamed to say I loved every damn second. As we were standing at the beginning of the parade where Adventureland and Frontierland meet, as soon as the final float passed, we moved back on to rides and adventure. We rode Splash Mountain almost immediately, and moved on to Seven Dwarf’s Mine Train (thanks to the FastPass System). As the light started to fade, we walked through Tomorrowland and back through Main Street hand in hand, still in disbelief at where we were.

We took the park bus back to our hotel, where we realised how much our feet hurt. As soon as we arrived at our room, we flopped, exhausted. Not to get the jet lag get the best of us, we took a tour of the hotel (once we could walk again), and grabbed dinner at the food court. We also bought refillable hotel mugs, which were hands down the best purchase of the holiday. Thanks to a little RFID chip at the bottom of the mug, we had free refills of any soft or hot drink at the hotel for the entire duration of our trip. So we grabbed some tooth rotting Coke and Mountain Dew, watched some American TV, and got ready to do it all again tomorrow.
Monday 4th November – Animal Kingdom


Jetlag was useful in getting us up early again, as today was our first experience of Extra Magic Hours. This is when a park opens a few hours early or stays open a few hours later for hotel guests. So we grabbed a quick breakfast to share, hopped on the extra early bus, and ten minutes later, we were at Animal Kingdom. Walking through Animal Kingdom is a completely different experience to Magic Kingdom, but just as awe-inspiring. The theming is second to none, and you really feel as though you have been taken out of a holiday destination, and dropped in a different land. After goggling at the size of the tree of life for a few minutes, we made our way over to Expedition Everest in Asia. As soon as we had ridden it, it was soon solidified as one of our favourite rides; it’s thrilling, has a great story, and we love a good backwards track.


One of the first things I booked when FastPasses were open was the earliest Kilimanjaro Safari I could find. If you don’t know, Animal Kingdom has a safari full of rescue animals that spans 110 acres; you could fit the whole of Magic Kingdom in that. As the animals are rescues, they aren’t used to heat, so you will tend to see more in the morning or evening when it is cooler. So, we jumped on for our morning FastPass. Kilimanjaro is one of the longest experiences at a Disney park, coming in at nearly half an hour, and is one of the most spectacular. We saw lions, giraffes, hippos, elephants, ostriches, and the list could go on. It is really one of the best experiences in Walt Disney World.



After Kilamanajro, we moved on to Gorilla Falls, and came up close with, guess what, gorillas (which was so wonderful!). We walked back through Asia to ride Kali River Rapids (make sure to pack ponchos), and topped for some exceptional macaroni and cheese from a food cart along the way. In perhaps a highlight (purely because Up is one of our favourite films as a couple), we saw Kevin and cast members walking around, which truly was a sight to behold.
It was then time for our next FastPass, which was Na’vi River Journey in Pandora. There are two rides in Pandora, and it’s almost impossible to get FastPasses for both, so we grabbed one for Flight of Passage for our next Animal Kingdom trip. This was our first experience at the new Disney World lands, along with Toy Story Land and Galaxy’s Edge, both at Hollywood Studios. I was utterly floored by the theming. The floor, plants, lights, and sounds all slowly changed as you enter the land. The mountains genuinely looked as though they were floating, and the little glimpses of bioluminescence were gorgeous. Na’vi River Journey as a ride was just as beautiful; we spent the whole time in silence, mouths wide open, in awe at it all. After the ride, we stopped at Pongu Pongu for our first alcoholic beverage of the trip – hey, it was after 12pm and we are both over twenty-one! Rory tried Hawkes’ Grog Ale, and I had the Rum Blossom; Apple and Pear frozen Limeade with Passion Fruit boba balls and Barcadi rum.


We sat down, watched the world go by, and soaked in the incredible theming. Just as we were about to leave, cast members with a robotic utility suit came out and we joined in the crowds watching and interacting with them.After being blown away by Pandora, we went back through Asia to use our FastPass for Expedition Everest (what can we say, we love it!). We picked up an ice cream and walked through DinoLand, Discovery Island, and back to Africa, where we saw monkeys swinging over our heads. At about 4pm, with aching feet, we returned home.


Rather foolishly, we succumbed to the jetlag, and napped for a few hours. In all honesty, it was needed. However fun and relaxing to the mind a holiday at Disney World is, it’s not relaxing on the body. Although our hotel had an excellent food court, and Disney had great food in general, we were not about spending lots of dollars on drinks and breakfasts. So, we booked an Uber and made our way over to Walmart. We picked up snacks, beer, wine, and any bits we forgot, and got caught in our first bought of Florida rain. When back at the hotel, the Britishness in us really didn’t fear the rain, so we jumped in the pool. Our hotel room was a two minutes walk away from the second, smaller pool, which meant less people! We then went back to the food court to grab dinner.


In all honesty, the food court at All Star Sport’s Resort was damn good. When we booked the trip, we knew we’d be staying in what Disney call a ‘budget’ hotel, but it never felt budget. Foodwise, you had your traditional theme park fare; burgers, hot dogs, pizzas. But they also offered pasta dishes, fish, steak, and meals to go like sandwiches. By the end of the trip, I had my go to meals of chicken strips and fries, chicken penne alfredo, margherita pizza, and salmon with mash and mac and cheese. It’s not the healthiest, but boy is it a good place to eat. They also have a great dessert section, complete with cupcakes, pastries, ice cream, and sundaes. The best part? It was (mostly) nut free! I only had to avoid the pastries, but everything else was mine for the taking (I’ve written more about eating with a nut allergy at WDW in this post here). We ended the day with ice cream sundaes, with the sun going down as we headed back to the hotel room.
Tuesday 5th November – Hollywood Studios


I’d be lying if I said I wasn’t excited to do everything on this trip, but if I had to pick one thing that piqued the excitement level, it would be Galaxy’s Edge – the new land in Hollywood Studios. Both me and my partner are huge Star Wars fans, and when we booked this trip, we weren’t even sure if Galaxy’s Edge would be open. Lucky for us, it was. With the jetlag mostly out of the way, we had breakfast in the room and got to Hollywood Studios a little later (i.e. just as the park opened – still early, but at least not rope drop).
We made our way to Sunset Boulevard for our first rides of the day, starting with Tower of Terror. Despite not having a FastPass, we risked the queue. If anything, this worked me up for the ride; since I last rode Tower of Terror, I developed a phobia of lifts thanks to getting stuck in one at university. However, it was a damn fun ride, even if my anxiety levels were through the roof until the first drop. We then jumped to the Rock n Roller Coaster Starring Aerosmith. As a child, this was my favourite coaster, and my boyfriend loves Aerosmith, so it was a win-win. After all the drops and spins, we settled down outside the coaster, and shared a churro and pretzel (they were so delicious, I still think about them to this day).


We meandered through Commissary Lane and Grand Avenue, taking in the sights, before heading to Galaxy’s Edge, also known as Black Spire Outpost, Batuu. Just like Pandora, the theming is spectacular; you genuinely don’t feel as if you are in Disney World anymore. The sounds are amazing; droids are having conversations, alien languages are being spoken out of windows, and there are moments where it sounds like spaceships are flying right over your head! We walked through the markets, various food places, and shops, taking it all in. It is such an immersive land, and although the sounds and sights really help that, the characters really make it. We saw Kylo Ren and Stormtroopers walking through, and my stomach jolted. I was told off by the Stormtroopers for filming them, and we saw Rey hiding behind the Millennium Falcon to escape them. I honestly felt like a child again.


Speaking of the Millennium Falcon, yeah, this gal cried when she saw it. It’s a full, lifesize model of the Falcon, smack bang in the middle of Galaxy’s Edge. The queue for the ride Smuggler’s Run wraps round the Falcon, so we joined that. Now, as it was the newest ride (at the time), the queue was long, I mean over 90 minutes long. Still, as it wasn’t at it’s usual 120 minutes, we grabbed a space in the queue. However, after 45 minutes, something happened on the ride and we were all told to leave the queue; my guess is a guest fell ill or something similar. So we abandoned hope, and got lunch instead at the Backlot Express. I really wanted to go here for food as I had very clear fond memories of sitting with my family here. This was simple theme park fare, chicken strips and fries, but it did the job. We checked wait times on the My Disney Experience app, and with Smuggler’s Run down, the lines were all over an hour. So, we decided to head back to the hotel early. Do not fear reader, we would return to Hollywood Studios later that evening, as we had a reservation.


One dip in the pool and solid nap later, we found ourselves back at Hollywood Studios as evening was settling down. Since this morning, it had rained heavily, so the park was thinning out. Smuggler’s Run was back up with a wait time for under an hour, so we dashed into the queue. That’s when the rain started again. The air was so warm and the droplets were enormous. It started the thunder and lightning and was truly a sight to behold.
The queue of Smuggler’s Run is worth it alone. It takes place mostly in a hangar where various ships are being fixed. Porgs nests and blasters are dotted around the place, comms between characters and engineers play as you wait, and the ships light up and shake as if they are about to blast off. The best bit? You are given roles of pilot, gunner, or engineer, and are sent to wait in the Millennium Falcon’s famous communal area. Cue lots of grins and giggles from Star Wars fans. Yes, we took photos at the Dejarik Table. No, we have no regrets. For this ride, we were given the roles of Pilot and we were all sent into the cockpit. The overall aim of the ride is to steal Coaxium from the Empire and give it to the rebels in the Resistance. How well you do at your roles depends how successful you are in the ride. I was a terrible pilot. Still, we helped the Resistance and secured our favourite ride so far.


Once we left the Falcon, we ran to get into the queue for Oga’s Cantina as it was time for our reservation. It’s tricky to get a reservation for Oga’s and I am so happy that we did. When you are brought into the cantina, you are either given a seating area to share with others or are standing at the bar, and we were at the bar. There’s a two drink maximum per person, and each person has a maximum of 45 minutes per reservation. For our first drinks, Rory went for a lager, and I had the Rodion Ration; an apple flavoured jelly made with vodka, and complete with popping candy and boba balls. Whilst you drink, the robot R3X DJs and the bar staff sing and play games. The best moment was when R3X played the famous cantina song from A New Hope, and the entire bar erupted into dance. Rory then had the Outer Rim, made with tequila, and I had the T-16 Skyhopper made with vodka.

We left the cantina feeling slightly tipsy, thanks to the surprisingly strong drinks. I would thoroughly recommend getting a reservation for Oga’s if you can. Although the drinks were expensive, it was such a fun time and a great experience. With an even shorter queue, we jumped on Smuggler’s Run again, and this time, we were Engineers. This was a lot more fun, as you just had to press buttons each time they glowed! Then, the park was shutting down for the night, so we went back to the hotel via the food court and exhausted, settled down for the night.

Originally, I had planned one only post about my Florida trip, but I am so glad I have split this into three! Parts two and three will be coming up soon and cover EPCOT, Universal Studios, and goodies that you get as a Disney park’s guest. Do let me know what you think, and if you want any advice on booking a Florida trip, do let me know!
Rosie x

Leave a comment